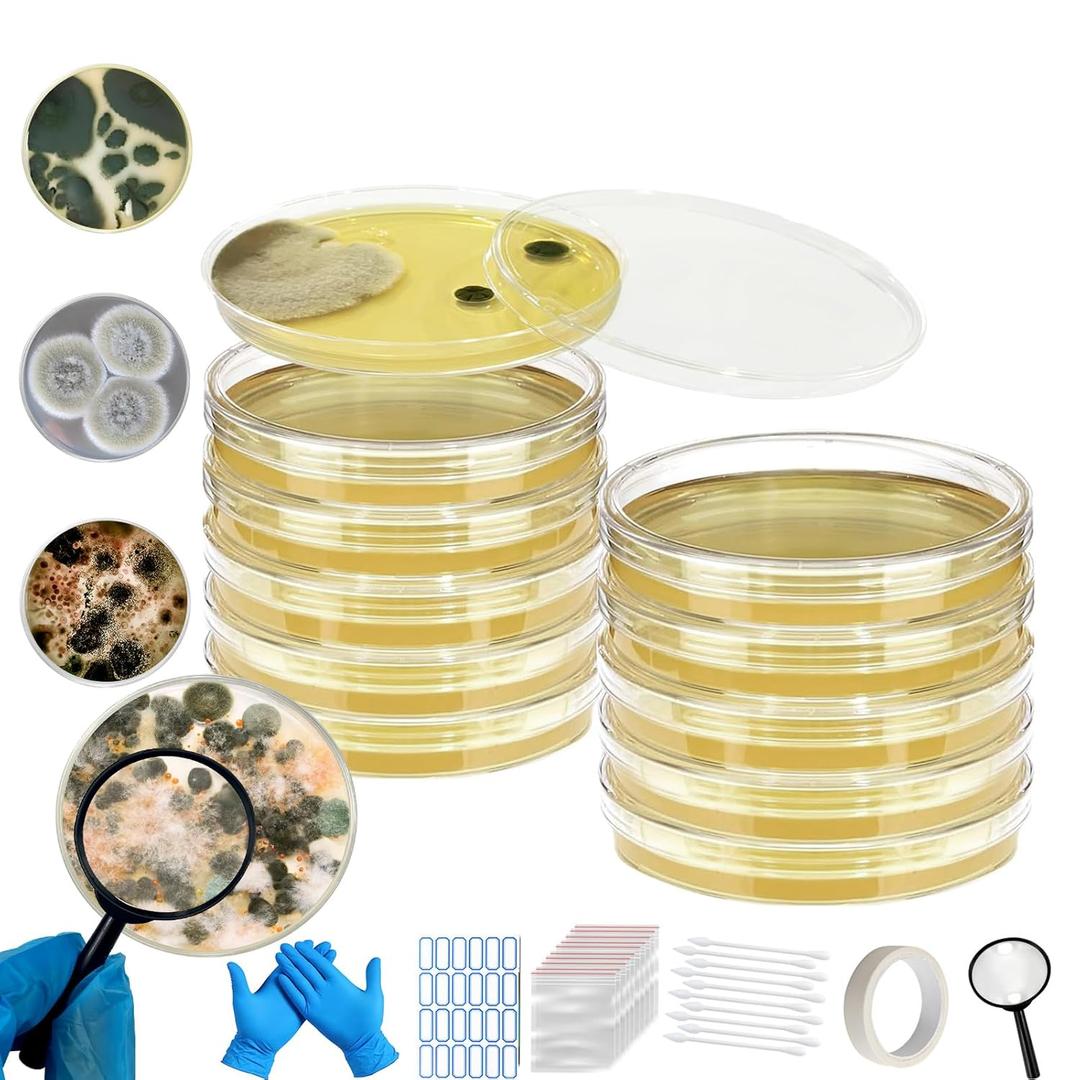
Mold Test Kit for Home,Mold Test Kit with 10 Indoor Mold air Test, Mold Detector for Home,Rapid Lab-Accurate Detection for Air & Surface Mold in Basements, Bathrooms & HVAC Systems

Mold Test Kit for Home,Mold Test Kit with 10 Indoor Mold air Test, Mold Detector for Home,Rapid Lab-Accurate Detection for Air & Surface Mold in Basements, Bathrooms & HVAC Systems
Condition: Appears New
Pickup Details
| Monday, Apr 6 | 11:00AM - 06:00PM (Appointment only) |
| Tuesday, Apr 7 | 11:00AM - 06:00PM (Appointment only) |
| Wednesday, Apr 8 | 11:00AM - 06:00PM (Appointment only) |
Product Details
| SKU | OLARRK0094494 |
| ASIN | B0F2MWHR8D |